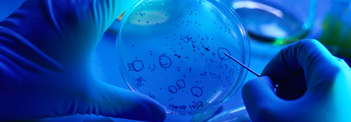

De directie Onderzoeksprogramma’s en -infrastructuren van Belspo financiert onderzoeksactiviteiten die federale bevoegdheden en de internationale verbintenissen van de federale regering ondersteunen.

De directie Ruimteonderzoek en -toepassingen van Belspo ondersteunt het Belgische wetenschaps- en industriebeleid op het gebied van ruimtevaartactiviteiten. Van aardobservatie tot raketlanceringen, via internationale programma’s of eigen initiatieven: ontdek hier enkele verwezenlijkingen van 2024.
De directie Federale, interfederale en internationale coördinatie organiseert het overleg tussen de Belgische overheden op het gebied van onderzoek en innovatie, om gemeenschappelijke standpunten te bepalen. In samenwerking met de Gemeenschappen en Gewesten coördineert zij de Belgische deelname aan Europese onderzoeksprogramma’s en -infrastructuren (Horizon Europe, Digital Europe, European Cooperation in Science and Technology, Eureka, European Strategy Forum on Research Infrastructures) en beheert zij de jaarlijkse Belgische bijdrage. Ze volgt de initiatieven van de Europese Onderzoeksruimte, de dossiers rond open wetenschap en coördineert meerdere internationale samenwerkingsovereenkomsten..







De directie MERI (Monitoring and Evaluation of Research and Innovation) is een statistische dienst die ook als onderzoeksinstelling door Eurostat is erkend. Ze is niet alleen bevoegd om officiële Belgische statistieken over onderzoek en innovatie te verzamelen, maar ook om onderliggende trends te analyseren en veranderingen in de cijfers te interpreteren.
